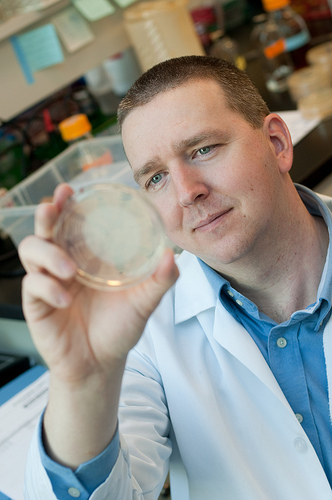

Kevin Allen (right, pretty much as shown), an assistant professor of food microbiology at the University of British Columbia who used to focus on perfecting his hockey skills through food microbiology graduate education but has more recently shifted his focus to preventing foodborne illness, writes:
As details of the Salmonella enterica serovar Tennessee contamination of hydrolysed vegetable protein (HVP) recall associated with Basic Foods Inc. (BFI), Nevada unravel, it is clear that many issues have played a role in this escalating and pervasive recall.
As details of the Salmonella enterica serovar Tennessee contamination of hydrolysed vegetable protein (HVP) recall associated with Basic Foods Inc. (BFI), Nevada unravel, it is clear that many issues have played a role in this escalating and pervasive recall.
The finding of S. Tennessee on processing equipment at the BFI production facility demonstrates serious deficiencies in their sanitation program; the delay in reporting and back-dating of the recall show a lack of proper risk communication and management; and the continued manufacture and shipping of potentially contaminated HVP product to food producers shows a serious lack of risk-based decision making. Together, this has the potential to result in a large number of continued recalls and smacks similar to the Peanut Corporation of America (PCA) recall in which S. Tennessee contaminated peanut products (2008) led to over 4,500 affected food products.
In both recalls, there appears to be a lack of responsibility associated with the food producers using these contaminated products. Because traditional microbiological testing requires highly-skilled laboratory technicians and an abundance of laboratory equipment, cost-cutting measures have routinely focused on decreased in-house testing of raw materials. Rather than microbiologically verifying the quality of individual raw materials which, admittedly, is a time-consuming process, food producers have increasingly relied on the vendor’s provision of a certificate of analysis stating that the product is microbiologically safe. In theory, this process of relying on vendor (i.e. BFI, PCA) assurances of microbiological acceptability should work providing that the vendor is producing the product hygienically and subsequently testing it appropriately. However, based on these two examples alone, food producers need to start verifying the microbiological quality of their raw materials, and stop relying on vendor’s assurances.
 A food producer who used HVP in a product should be able look back at that lot to see that yes, our company used it, we tested it prior to use and found no pathogen contamination. Based on this approach, all production lots that were associated with production would also be tested and shown pathogen-free prior to retail distribution. However, cost-cutting, production requirements, and a simple willingness to assume microbiological safety of raw materials based on third-party assurances have once again severely impacted the food industry in a negative manner. Maybe it’s time food producers go back to the basics, and realize that microbiological testing of raw materials is not a waste of time and money, but rather a critical step in providing microbiologically safe foods to the public.
A food producer who used HVP in a product should be able look back at that lot to see that yes, our company used it, we tested it prior to use and found no pathogen contamination. Based on this approach, all production lots that were associated with production would also be tested and shown pathogen-free prior to retail distribution. However, cost-cutting, production requirements, and a simple willingness to assume microbiological safety of raw materials based on third-party assurances have once again severely impacted the food industry in a negative manner. Maybe it’s time food producers go back to the basics, and realize that microbiological testing of raw materials is not a waste of time and money, but rather a critical step in providing microbiologically safe foods to the public.

 The Wall Street Journal
The Wall Street Journal .jpg) Basic Food makes a flavor enhancer called hydrolyzed vegetable protein, or HVP. The FDA report said the company first learned salmonella was present at its processing facility for HVP on Jan. 21. The company continued to distribute the ingredients until Feb. 15. A representative for the company wasn’t immediately available to comment. The company hasn’t responded to earlier requests for comment.
Basic Food makes a flavor enhancer called hydrolyzed vegetable protein, or HVP. The FDA report said the company first learned salmonella was present at its processing facility for HVP on Jan. 21. The company continued to distribute the ingredients until Feb. 15. A representative for the company wasn’t immediately available to comment. The company hasn’t responded to earlier requests for comment. The course devotes a lot of time to food safety risk communication and Kevin, being a bright guy, thought, CBC is about to call and ask me about Salmonella in hydrolyzed vegetable protein, I’ll check in with Doug for some tips.
The course devotes a lot of time to food safety risk communication and Kevin, being a bright guy, thought, CBC is about to call and ask me about Salmonella in hydrolyzed vegetable protein, I’ll check in with Doug for some tips.